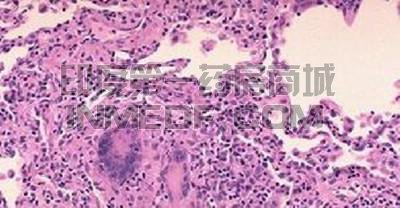
利妥昔单抗

【资讯导读】 肉芽肿性多血管炎(Granulomatosis with polyangiitis,GPA)又称韦格纳肉芽肿(WG),病变范围广泛,累及小动脉、静脉及毛细血管,偶尔累及大动脉,其病理以血管壁的炎症为特征,主要侵
肉芽肿性多血管炎(Granulomatosis with polyangiitis,GPA)又称韦格纳肉芽肿(WG),病变范围广泛,累及小动脉、静脉及毛细血管,偶尔累及大动脉,其病理以血管壁的炎症为特征,主要侵犯上、下呼吸道和肾脏,属自身免疫性疾病。
肉芽肿性多血管炎的治疗取决于疾病严重程度,治疗主要是用皮质激素(如泼尼松)加免疫抑制剂。
GPA的治疗方案分为诱导缓解和维持治疗2个阶段。
诱导缓解药物
1、环磷酰胺(Cyclophosphamide,CTX)
2、吗替麦考酚酯(Mycophenolate Mofetil,MPA)
维持治疗药物
3、甲氨喋呤(Methotrexate,MTX)
4、硫唑嘌呤(Azathioprine,AZA)

5、利妥昔单抗(Rituximab)对于难治性或复发GPA的患者。
6、Tavneos(avacopan)是一款口服给药的选择性补体C5a受体(C5aR)抑制剂。